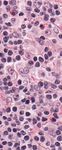
Teaching Cases in Hematology: A Virtual Slide Atlas - Jason C. Ford, MD, FRCP(C) Sophia Wong 2009 - Pathology and Laboratory ...
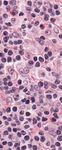
Teaching Cases in Hematology: A Virtual Slide Atlas - Jason C. Ford, MD, FRCP(C) Sophia Wong 2009 - Pathology and Laboratory ...

Teaching Cases in Hematology: A Virtual Slide Atlas - Jason C. Ford, MD, FRCP(C) Sophia Wong 2009 - Pathology and Laboratory ...
←
→
Page content transcription
If your browser does not render page correctly, please read the page content below
Teaching Cases in Hematology: A Virtual Slide Atlas Jason C. Ford, MD, FRCP(C) Sophia Wong 2009 Instructions updated 2021
Welcome to the Hematopathology Case-Based Atlas. The Atlas is a collection of classic hematology cases, representing both adult and pediatric conditions. Each case in the Atlas consists of a concise patient history, corresponding CBC findings and other pertinent laboratory data, as well as digitized slide(s) of peripheral blood smears, bone marrow aspirates/biopsies, lymph node biopsies, and/or other relevant histological tissues. The slides are annotated to highlight important diagnostic features, although we encourage you to review the slides with the annotations turned “off” (which is our default setting) just as if you were reviewing these slides in the clinical laboratory. For each case, please first review the case history and CBC findings, and then view the slides. The “Instructions for Viewing Slides”, on the next pages, explain how to look at the digital slides, and how to access the slide annotations. After you have made your own morphological diagnosis for each case, you will be able to review the correct diagnosis and a brief description of each disorder. The majority of the cases are from the teaching files of the BC Children’s Hospital Division of Hematopathology. We would like to thank our patients and our colleagues for making these cases available to us. In particular, we would like to extend our sincere gratitude to Dr. Bonnie Massing, an expert hematopathologist and a great teacher. Jason Ford Sophia Wong Summer 2009 The links to the slides were updated in February 2021 because the slide database was upgraded due to the elimination of Flash. A login and password are now required as part of the upgrade. If you have any questions or comments about this Atlas, please let us know at hdyck@pathology.ubc.ca Helen Dyck Manager & Curator The David F Hardwick Pathology Learning Centre UBC Dept. of Pathology & Laboratory Medicine
Instructions for Viewing Slides
Updated February 2021
New username: Hemepath New password:
anemia
The slides can now be viewed using the
Web Viewer, which is usable in all updated
browsers. You may also use the free Aperio
Imagescope program available from Leica.
https://www.leicabiosystems.com/digital-
pathology/manage/aperio-imagescope/
To view slides:
Clicking the links will open the slide in Web
Viewer. To switch to ImageScope (if you
have it installed) Click on the icon of a slide
plus the magnifying glass (Black arrow).
Change magnification by scrolling or by
using the slider or selector at the bottom of
the page. The wheel allows you to realign
the image.To View Annotations in ImageScope:
The most informative way of viewing the annotations is using ImageScope. They do
show up in Web Viewer but there is more functionality in ImageScope.
Click on the link under “Annotated Slides” and switch to ImageScope.
1. When the slide views there are no annotations marked at all. This is a great
place to start viewing the slide.
2. If you are having trouble locating abnormalities, you can go to “View” and click
on “Annotations,” or find this icon on the toolbar and click on it:
3. A box should view up that looks similar to the following:
Eye
icon Layers
A. Layers lets you go to areas of interest without any markings present.
Click on any region to go to that part of the slide. It will automatically zoom to
an appropriate magnification.
B. Once you click on the eye icon the marking will show up in all views.
The layer attributes lets you know what is marked.Hemepath Case 1: 5-Year-Old Boy
HISTORY
A 5-year-old boy presents with exquisitely painful fingers and toes. The family emigrated
from West Africa 6 months ago.
CBC
Hgb (g/L) Low
MCV N
Reticulocyte Count High
WBC N
Plt N
View Slides
No Annotations: (To use Image Scope click the image of the slide with a magnifying glass)
To view slide with web browser click here
For Annotated slides
To view slide click here
View Discussion and Diagnosis
Link
3Hemepath Case 2: 3-Year-Old Girl
HISTORY
A 3-year-old girl, who had an upper respiratory tract infection 2 weeks ago, is noted to
have purple, pinpoint hemorrhages in her buccal mucosa and several bruises on her
legs. She has experienced 4 episodes of nosebleeds in the last week.
On physical exam, the spleen and liver are both non-palpable. No lymphadenopathy is
noted.
CBC
Hgb (g/L) N
MCV N
WBC N
Plt Low
View Slides
No Annotations: (To use Image Scope click the image of the slide with a magnifying glass)
To view slide with web browser click here
For Annotated slides:
To view slide with Image Scope click here
View Discussion and Diagnosis
Link
4Hemepath Case 3: 5-Year-Old Boy
HISTORY
A 5-year-old Caucasian boy is brought in by his mother, who notes that her son has
appeared quite pale in the last week. He is constantly tired and takes several naps a
day, and complains that he can no longer play tag with his friends because he “can’t
breathe” when he runs.
Physical exam reveals a diffuse petechial rash and several large bruises over his trunk
and extremities. A liver edge is palpated 2.5 cm below the costal margin. The spleen is
also palpable.
CBC
Hgb (g/L) Low
MCV N
Reticulocyte Count Low
WBC High
Plt Low
View Slides
No Annotations: (To use Image Scope click the image of the slide with a magnifying glass)
To view slide with web browser click here
For Annotated slides:
To view slide click here
View Discussion and Diagnosis
Link
5Hemepath Case 4: 11-Year-Old Boy
HISTORY
An 11-year-old boy visits his family physician because of a sprained ankle. The
physician, noting the boy to be thin and pale, conducts a full physical exam. The
patient’s spleen is grossly enlarged (palpable 8 cm below the costal margin) and firm,
but non-tender. Lymph nodes are non-palpable.
Upon further questioning, the boy admits that he has felt weak for the past few months,
and needs much more sleep than before. He also remarks that his gums frequently
bleed when he brushes his teeth.
CBC
Hgb (g/L) Low
MCV N
WBC High
Plt High
View Slides
No Annotations: (To use Image Scope click the image of the slide with a magnifying glass)
To view slide with web browser click here
For Annotated slides:
To view slide click here
View Discussion and Diagnosis
Link
6Hemepath Case 5: 67-Year-Old Male
HISTORY
A 67-year-old man presents with a diffuse scaly erythematous rash throughout his entire
body, including his palms and soles. The rash is extremely itchy. He has had several
red, scaly patches on his left buttock and his right axilla for the past 5 years, which were
pruritic at times. The patient assumed these skin lesions to be related to eczema, and
thus never sought medical attention.
On physical exam, multiple large, hard, non-mobile lymph nodes are palpated in the
cervical, axillary, and groin regions. The patient is noted to be shivering during the
entire exam.
CBC
Hgb (g/L) N
MCV N
WBC High
Plt N
View Slides
No Annotations: (To use Image Scope click the image of the slide with a magnifying glass)
To view slide with web browser click here
For Annotated slides:
To view slide click here
View Discussion and Diagnosis
Link
7Hemepath Case 6: 15-Year-Old Girl
HISTORY
A 15-year-old girl visits her family physician for an annual physical exam and a CBC is
ordered.
The girl returns for a follow-up because of the CBC results (see below). Upon focused
questioning, the patient notes that her menses have always been heavy (8-9 days per
cycle). She also remembers bleeding profusely when a tooth was extracted at the
dentist’s office. The girl says that this amount of bleeding from dental visits is common
in her family – both her mom and her uncle have similar complaints.
CBC
Hgb (g/L) N
MCV N
WBC N
Plt Low
View Slides
No Annotations: (To use Image Scope click the image of the slide with a magnifying glass)
To view slide with web browser click here
For Annotated slides:
To view slide click here
View Discussion and Diagnosis
Link
8Hemepath Case 7: 7-Year-Old Boy
HISTORY
A 7-year-old boy presents with a large abdominal mass and a 4-day history of fatigue
and weakness. Past medical history is unremarkable.
Physical exam reveals a large, non-tender mass in the lower abdomen,
hepatosplenomegaly, and multiple swollen, non-tender lymph nodes in the
submandibular and cervical regions. Peripheral blood and bone marrow are studied.
CBC
Hgb (g/L) Low
MCV N
Reticulocyte Count Low
WBC High
Plt Low
View Slides
No Annotations: (To use Image Scope click the image of the slide with a magnifying glass)
To view slide 1 with web browser click here
To view slide 2 with web browser click here
To view slide 3 with web browser click here
For Annotated slides:
To view slide 1 click here
To view slide 2 click here
To view slide 3 click here
View Discussion and Diagnosis
Link
9Hemepath Case 8: 3-Year-Old Girl
HISTORY
A 3-year-old girl is brought in by her mother, having become increasingly drowsy and
lethargic over the past week. The child has experienced chills, a mild cough, and a high
fever of 40°C that has waxed and waned for the entire week. She also refuses to eat,
and has vomited twice. The symptoms began approximately 2 weeks after the family
returned from a vacation to Nepal. On the last day of their trip, their son pointed out
that there was a hole in their mosquito net.
CBC
Hgb (g/L) Low
MCV N
Reticulocyte Count High
WBC Low
Plt Low
View Slides
No Annotations: (To use Image Scope click the image of the slide with a magnifying glass)
To view slide with web browser click here
For Annotated slides:
To view slide click here
View Discussion and Diagnosis
Link
10Hemepath Case 9: 4-Year-Old Boy
HISTORY
A 4-year-old boy is brought in by his father. The child has eaten clay from the
playground on several occasions and demands “only ice” during dinners. As well, the
boy is still unable to speak in sentences and expresses no interest when his parents read
simple story books to him. There has been no blood observed in the stools or urine,
and the boy has not had any episodes of vomiting. A dietary history reveals that the
entire family is lacto-vegetarian and the child has never consumed any meat;
additionally, the boy loves cow’s milk and drinks up to 6 large glasses per day.
On physical examination, the child appears pale and is noted to use his accessory
muscles for respiration, even at rest. His tongue is red, shiny, and smooth, and the
corners of his mouth are red and macerated. His fingernails are curved upwards,
resembling a spoon. On cardiac exam, the boy’s HR is 140 bpm and auscultation
reveals a systolic ejection murmur at the upper left sternal border.
CBC
Hgb (g/L) Low
MCV Low
RDW High
Reticulocyte Count Low
WBC N
Plt High
View Slides
No Annotations: (To use Image Scope click the image of the slide with a magnifying glass)
To view slide with web browser click here
For Annotated slides:
To view slide click here
View Discussion and Diagnosis
Link
11Hemepath Case 10: 2-Month-Old Girl
HISTORY
A 2-month-old girl is brought in by her mother. The baby has been lethargic, irritable,
and has not gained adequate weight. There is no history of illnesses or any episodes of
fever, diarrhea, or vomiting. The girl was the product of a healthy pregnancy and full-
term home delivery; however, an atrial septal defect was diagnosed at birth.
On physical exam, the patient appears pale and listless. She is noted to have wide-
spaced eyes, a short, upturned nose, and a thick upper lip. Both thumbs are subluxed.
CBC
Hgb (g/L) Low
MCV High
Reticulocyte Count Markedly reduced
WBC N
Plt N
View Slides
No Annotations: (To use Image Scope click the image of the slide with a magnifying glass)
To view slide 1 with web browser click here
To view slide 2 with web browser click here
To view slide 3 with web browser click here
For Annotated slides:
To view slide 1 click here
To view slide 2 click here
To view slide 3 click here
View Discussion and Diagnosis
Link
12Hemepath Case 11: 5-Year-Old Boy
HISTORY
A 5-year-old boy presents with dark urine after walking home from kindergarten with
his mother on a cold, snowy day. The child experienced diarrhea and vomiting 3 weeks
ago, and was diagnosed with a GI viral infection. Since then, he has complained of
feeling “full all the time”, and experiences occasional abdominal discomfort. His mother
also notices that he rarely plays with his siblings, but instead, takes naps on the couch.
The child has always been very energetic in the past.
Physical exam reveals a pale-looking boy with an enlarged spleen palpable 3-4 cm below
the left costal margin.
CBC
Hgb (g/L) Low
MCV N
Reticulocyte Count High
WBC N
Plt N
OTHER LABORATORY FINDINGS
Urine dipstick for blood (+)
LDH High
Direct Coombs Test (+) complement only
Biphasic Donath-Landsteiner Test (+)
View Slides
No Annotations: (To use Image Scope click the image of the slide with a magnifying glass)
To view slide with web browser click here
For Annotated slides:
To view slide click here
View Discussion and Diagnosis
Link
13Hemepath Case 12: Newborn Male
HISTORY
A newborn male, of African descent on his father’s side (mother is Caucasian), is
severely jaundiced. The pregnancy and delivery were unremarkable. Family history
reveals that the father has G6PD deficiency and hereditary elliptocytosis.
The baby is now 2-day-old with a very high bilirubin level.
CBC
Hgb (g/L) Low
MCV Low
RDW High
Reticulocyte Count High
WBC N
Plt N
View Slides
No Annotations: (To use Image Scope click the image of the slide with a magnifying glass)
To view slide with web browser click here
For Annotated slides:
To view slide click here
View Discussion and Diagnosis
Link
14Hemepath Case 13: 4-Month-Old Girl
HISTORY
A 4-month-old baby girl of Mediterranean descent is brought in by her father as she
appears pale and has not been gaining weight. The child also has a “lump” in her upper
left abdomen.
On physical examination, the girl is noted to be lethargic. Her skin is pale and her
sclera has a tinge of yellow. The zygomatic bones are disproportionably larger than the
rest of her facial bones. The spleen is palpable 5 cm below the left costal margin.
CBC
Hgb (g/L) Low
MCV Low
RBC count High
Reticulocyte Count High
WBC N
Plt N
OTHER LABORATORY FINDINGS
HbA2 Increased
HbF Increased
View Slides
No Annotations: (To use Image Scope click the image of the slide with a magnifying glass)
To view slide with web browser click here
For Annotated slides:
To view slide click here
View Discussion and Diagnosis
Link
15Hemepath Case 14: 7-Year-Old Girl
HISTORY
A 7-year-old girl presents with an upper respiratory tract infection. Her mother is
concerned that the girl’s eyes have turned “yellow”. This has happened before several
times, and always occurred when the girl was sick with a viral infection. The mother
also comments that her child is paler than the rest of the family members, and tires
easily when playing outdoors. Birth history is unremarkable except for neonatal
jaundice that lasted for 1 week. Family history reveals that the family migrated from
Norway 5 years ago, and the father had a splenectomy in his 20s.
Splenomegaly is noted on physical examination.
CBC
Hgb (g/L) Low
MCV N
MCHC High
Reticulocyte Count High
RDW High
WBC N
Plt N
OTHER LABORATORY FINDINGS
Osmotic Fragility Test: Increased fragility
Flow for Eosin-5-maleimide: Reduced fluorescence
View Slides
No Annotations: (To use Image Scope click the image of the slide with a magnifying glass)
To view slide with web browser click here
For Annotated slides:
To view slide click here
View Discussion and Diagnosis
Link
16Hemepath Case 15: 22-Year-Old Male
HISTORY
A 22-year-old African-Canadian male presents with a 3-day history of extreme fatigue
and weakness, and “cola”-colored urine. His girlfriend comments that his skin and eyes
have also become increasingly yellow.
The patient has always been in good health, apart from severe acne for which he
started taking sulfacetamide 5 or 6 days ago. He remarks that his brother had similar
symptoms while preparing for a trip to Haiti.
CBC
Hgb (g/L) Low
MCV N
Reticulocyte Count High
WBC N
Plt N
View Slides
No Annotations: (To use Image Scope click the image of the slide with a magnifying glass)
To view slide with web browser click here
For Annotated slides: (see instructions in Introduction for viewing annotations)
To view slide click here
View Discussion and Diagnosis
Link
17Hemepath Case 16: 7-Month-Old Boy
HISTORY
A 7-month-old baby boy of Italian ancestry is brought in by his mother as he is not gaining
adequate weight. Also, he is not rolling over on his own yet, and does not seem able to
support his own head very well.
On physical exam, both liver and spleen are noted to be enlarged. Cardiac exam reveals
moderate pedal edema and a systolic ejection murmur.
CBC
Hgb (g/L) Low
MCV High
Reticulocyte Count N
WBC N
Plt N
OTHER LABORATORY FINDINGS
Serum Fe High
Serum Ferritin High
Serum Bilirubin Mild
increase Ham’s Test (+)
Sucrose Lysis Test (-)
View Slides
No Annotations: (To use Image Scope click the image of the slide with a magnifying glass)
To view slide 1 with web browser click here
To view slide 2 with web browser click here
For Annotated slides:
To view slide 1 click here
To view slide 2 click here
View Discussion and Diagnosis
Link
18Hemepath Case 17: 5-Year-Old Boy
HISTORY
A 5-year-old Chinese-Canadian boy presents with recurring abdominal pain localized to
the right upper quadrant. The discomfort is not associated with meals. Past medical
history is unremarkable except that the boy’s skin and sclera have “always” been slightly
jaundiced.
Physical exam reveals a mildly jaundiced boy in no apparent distress. On abdominal
exam, an enlarged, firm, non-tender spleen is palpated 7 cm below the left costal
margin. A positive Murphy’s sign is also elicited.
CBC
Hgb (g/L) Low
MCV N
Reticulocyte Count Very high
WBC N
Plt N
OTHER LABORATORY FINDINGS
Osmotic Fragility Test N
Coombs Test (-)
View Slides
No Annotations: (To use Image Scope click the image of the slide with a magnifying glass)
To view slide with web browser click here
For Annotated slides:
To view slide click here
View Discussion and Diagnosis
Link
19Hemepath Case 18: 13-Year-Old Girl
HISTORY
A 13-year-old girl presents with jaundice, marked hepatosplenomegaly, and prominent
frontal bossing. Both parents are immigrants from Thailand.
CBC
Hgb (g/L) Low
MCV Low
Reticulocyte Count High
WBC N
Plt N
OTHER LABORATORY FINDINGS
Bilirubin High
Serum Fe N
Serum Ferritin N
View Slides
No Annotations: (To use Image Scope click the image of the slide with a magnifying glass)
To view slide 1 with web browser click here
To view slide 2 with web browser click here
For Annotated slides:
To view slide 1 click here
To view slide 2 click here
View Discussion and Diagnosis
Link
20Hemepath Case 19: 63-Year-Old Female
HISTORY
A 63-year-old female presents with fatigue and “reduced energy” for two weeks. She
complains of being out of breath from taking a stroll in the park, and notices that her
heart races when she watches TV.
On physical exam, the patient appears pale and has a fever of 38.5°C. Her gingivae are
swollen and hemorrhagic, and a petechial rash is noted on her left arm. Both liver and
spleen are found to be enlarged.
CBC
Hgb (g/L) Low
MCV N
Reticulocyte Count Low
WBC High
Plt Low
View Slides
No Annotations: (To use Image Scope click the image of the slide with a magnifying glass)
To view slide with web browser click here
For Annotated slides:
To view slide click here
View Discussion and Diagnosis
Link
21Hemepath Case 20: 3-Year-Old Girl
HISTORY
A 3-year-old girl who recently emigrated from Puerto Rico is brought in by her mother
over concerns that the child is not gaining adequate weight. She is always tired, and
sleeps through most of the day. The girl is not a picky eater and enjoys foods from all
food groups. However, she is known to have tropical sprue and has only begun
receiving treatment recently.
On physical examination, the girl appears tired, quite thin, and slightly jaundiced. The
corners of her mouth are red and cracked, and her tongue is very red and swollen. Mild
bruising is observed on her lower legs. No lymphadenopathy is noted. Findings from
the neurological examination are normal.
CBC
Hgb (g/L) Low
MCV High
Reticulocyte Count Low
WBC Low
Plt Low
View Slides
No Annotations: (To use Image Scope click the image of the slide with a magnifying glass)
To view slide with web browser click here
For Annotated slides:
To view slide click here
View Discussion and Diagnosis
Link
22Hemepath Case 21: 9-Year-Old Boy
HISTORY
A 9-year-old boy of Ashkenazi Jewish ancestry complains of pain in his left arm. There
has been no history of trauma or injury.
For the past year, the patient has been taking increasingly longer naps in the afternoons
as he always feels tired. He has stopped playing sports with his friends as he feels out
of breath when he runs. About 8 months ago, he began having regular nosebleeds
(about 1 episode per month) and acquires frequent bruises on his legs, although he
doesn’t remember injuring himself.
On physical examination, the patient appears pale and listless. Localized tenderness and
swelling are noted on his left forearm, and he winces with pain during gentle palpation.
There is no skin breakage. Additionally, several ecchymoses are noted on the anterior
part of his shins bilaterally. The spleen is found to be severely enlarged, with the tip
protruding into the pelvic cavity.
CBC
Hgb (g/L) Low
MCV N
Reticulocyte Count N
WBC Low
Plt Low
View Slides
No Annotations: (To use Image Scope click the image of the slide with a magnifying glass)
To view slide 1 with web browser click here
To view slide 2 with web browser click here
For Annotated slides:
To view slide 1 click here
To view slide 2 click here
View Discussion and Diagnosis
Link
23Hemepath Case 22: 1-Year-Old Boy
HISTORY
A 1-year-old boy is brought in by his mother. He has not gained adequate weight and
is noticeably shorter than the other children of his age. He also does not respond when
his name is called, and still has not spoken his first words. Over the past few months,
she has noticed a “hump” in his lower back which has gradually increased in size. She
also remarks that his facial features seem to be changing and he no longer resembles
his parents. The boy was born with an umbilical hernia and has had chronic rhinitis “his
entire life”. He also had an ear infection 3 months ago.
On physical examination, the boy is noted to have a prominent forehead, large eyes
with marked corneal clouding, a flattened nasal bridge, and a large tongue. He is
unresponsive to both auditory and visual stimuli. The rest of the exam reveals
hepatosplenomegaly and mild deformation of the lower spine and pelvis.
CBC
Hgb (g/L) N
MCV N
WBC N
Plt Low
View Slides
No Annotations: (To use Image Scope click the image of the slide with a magnifying glass)
To view slide with web browser click here
For Annotated slides:
To view slide click here
View Discussion and Diagnosis
Link
24Hemepath Case 23: 52-Year-Old Male
HISTORY
A 52-year-old male presents with a gradual onset of fatigue and abdominal discomfort.
He has lost 3 kg in the past month and complains of drenching night sweats,
approximately 1-2 episodes per week. He has a persistent mild fever and gets sick very
easily, although he was previously in good health. Whenever he eats, he feels full after
only a few bites.
Physical examination reveals a pale, tired man with mild tachycardia. Massive
enlargement of the spleen, with the tip palpable in the pelvis, is noted. The liver is firm
and palpated 7 cm below the right costal margin. No lymphadenopathy is found.
CBC
Hgb (g/L) Mildly low
MCV N
Reticulocyte Count Low
WBC N
View Slides
No Annotations: (To use Image Scope click the image of the slide with a magnifying glass)
To view slide 1 with web browser click here
To view slide 2 with web browser click here
To view slide 3 with web browser click here
For Annotated slides:
To view slide 1 click here
To view slide 2 click here
To view slide 3 click here
View Discussion and Diagnosis
Link
25Hemepath Case 24: 33-Year-Old Female
HISTORY
A 33-year-old female pregnant with her first child (26 weeks 2 days gestation) notices
decreased movements from her fetus over the past few days. This morning, her uterus
felt slightly tender. The fetal heart strip shows a sinusoidal pattern. A Kleihauer test is
performed.
View Slides
No Annotations: (To use Image Scope click the image of the slide with a magnifying glass)
To view slide with web browser click here
For Annotated slides:
To view slide click here
View Discussion and Diagnosis
Link
26Hemepath Case 25: 60-Year-Old Male
HISTORY
A 60-year-old male complains of frequent episodes of headache and dizziness that are
gradually worsening in severity. Three months prior he stopped playing golf with his
friends as he became increasingly dyspneic from walking, and his vision often became
blurred.
On physical examination, the patient’s body appears quite erythematous, and his face is
noted to be red and swollen. Fundoscopy reveals plethora of the retinal veins. His
spleen is firm, non-tender, and palpable 6 cm below the left costal margin. Several
bruises are observed on his lower legs.
CBC
Hgb (g/L) High
RBC High
MCV Low
WBC High
Plt High
View Slides
No Annotations: (To use Image Scope click the image of the slide with a magnifying glass)
To view slide with web browser click here
For Annotated slides:
To view slide click here
View Discussion and Diagnosis
Link
27Hemepath Case 26: 3-Year-Old Boy
HISTORY
A 3-year-old boy is brought in by his mother. He started complaining about pain in his
left hip a week ago, and developed a limp over the past few days. This morning, he can
no longer walk and is having difficulty standing. The mother also notices a bruise
around his left eye although there is no history of trauma.
On physical examination, the child appears ill and thin. A hard mass is palpated in his
abdomen.
CBC
Hgb (g/L) Low
MCV N
Reticulocyte Count Low
WBC Low
Plt Low
View Slides
No Annotations: (To use Image Scope click the image of the slide with a magnifying glass)
To view slide with web browser click here
For Annotated slides:
To view slide click here
View Discussion and Diagnosis
Link
28Hemepath Case 27: 55-Year-Old Female
HISTORY
A 55-year-old female from Japan presents with a 1-week history of papules and nodules.
The lesions began on her trunk and quickly spread throughout the entire body. The
patient also complains of fatigue, constipation, and increased urinary frequency for the
past several months. Physical examination reveals cervical, axillary, and inguinal
lymphadenopathy, as well as hepatosplenomegaly.
CBC
Hgb (g/L) N
MCV N
WBC High
Plt N
OTHER LABORATORY FINDINGS
LDH High
Serum Ca High
View Slides
No Annotations: (To use Image Scope click the image of the slide with a magnifying glass)
To view slide with web browser click here
For Annotated slides:
To view slide click here
View Discussion and Diagnosis
Link
29Hemepath Case 28: Newborn Male
HISTORY
A newborn male with a congenital heart defect undergoes a successful surgical repair.
Several hours later, the patient is found to have a post-operative pleural effusion. The
effusion is tapped.
The baby’s CBC is normal.
View Slides
No Annotations: (To use Image Scope click the image of the slide with a magnifying glass)
To view slide with web browser click here
For Annotated slides:
To view slide click here
View Discussion and Diagnosis
Link
30Hemepath Case 29: 13-Year-Old Male
HISTORY
A 13-year-old male presents with a 1-month history of right-sided cervical
lymphadenopathy, as well as test results suggestive of hepatitis. The node is aspirated,
and “Hodgkin-like cells” are identified. The node is subsequently excised.
CBC
Hgb (g/L) N
MCV N
WBC High
Plt N
View Slides
No Annotations: (To use Image Scope click the image of the slide with a magnifying glass)
To view slide with web browser click here
For Annotated slides:
To view slide click here
View Discussion and Diagnosis
Link
31Hemepath Case 30: 23-Year-Old Female
HISTORY
A 23-year-old female presents with a 1-week history of fatigue, headache, and muscle
pain. She also complains of anorexia and intermittent episodes of nausea and vomiting.
Past medical history is unremarkable.
On physical examination, a single firm, painful and mobile lymph node is palpated in the
posterior cervical region.
CBC
Hgb (g/L) N
MCV N
WBC N
Plt N
View Slides
No Annotations: (To use Image Scope click the image of the slide with a magnifying glass)
To view slide with web browser click here
For Annotated slides:
To view slide click here
View Discussion and Diagnosis
Link
32Hemepath Case 31: 19-Year-Old Male
HISTORY
A 19-year-old male, an exchange student from Africa, presents with multiple bilateral
painless and mobile enlarged cervical lymph nodes. He reports a fever for the past
week and weight loss of 2 pounds during this time.
CBC
Hgb (g/L) Low
MCV N
WBC High
Plt N
OTHER LABORATORY FINDINGS
ESR High
γ-Globulin High, non-clonal
View Slides
No Annotations: (To use Image Scope click the image of the slide with a magnifying glass)
To view slide with web browser click here
For Annotated slides:
To view slide click here
View Discussion and Diagnosis
Link
33Hemepath Case 32: 17-Year-Old Male
HISTORY
A 17-year-old male presents with recurrent fever and chills, as well as weight loss of 2 kg,
over the past 3 weeks. Four days ago, he started complaining of pain in his left wrist. He
was previously in good health, with no significant past medical history or family medical
history.
Physical examination reveals an ill-appearing adolescent male with a swollen left wrist,
tender to palpation. Several red, warm, pruritic nodules are observed on his right thigh.
Axillary and inguinal lymphadenopathy are also noted. Radiologic imaging of his left wrist
shows a 3 cm osteolytic lesion in the ulnar head.
CBC
Hgb (g/L) Low
MCV N
Reticulocyte Count Low
WBC Low
Plt Low
View Slides
No Annotations: (To use Image Scope click the image of the slide with a magnifying glass)
To view slide 1 with web browser click here
To view slide 2 with web browser click here
To view slide 3 with web browser click here
For Annotated slides:
To view slide 1 click here
To view slide 2 click here
To view slide 3 click here
View Discussion and Diagnosis
Link
34Hemepath Case 33: 65-Year-Old Female
HISTORY
A 65-year-old female visits her family physician. She is concerned as her fingers turn
purple and become painful when she goes out for her morning jog. This is especially
severe during the winter months. She also notices that she tires easily, and can no
longer run as far as she used to. Her urine is sometimes tea-colored after one of these
episodes.
Physical examination reveals a pale-looking female in no apparent distress. She is
slightly tachycardic. Her hands and earlobes are cold to the touch, and her spleen is
slightly enlarged.
CBC
Hgb (g/L) Low
MCV N
Reticulocyte Count High
WBC N
Plt N
OTHER LABORATORY FINDINGS
LDH High
Bilirubin High
View Slides
No Annotations: (To use Image Scope click the image of the slide with a magnifying glass)
To view slide with web browser click here
For Annotated slides:
To view slide click here
View Discussion and Diagnosis
Link
35Hemepath Case 34: 21-Year-Old Male
HISTORY
A 21-year-old male presents with a 1-week history of intermittent chest pain and
shortness of breath. Several times in the past week, he has woken up in the middle of
the night drenched in sweat. He has not weighed himself recently, but notices that his
favorite jeans seem loose compared to before.
On examination, the patient appears weak and pale. A petechial rash is noted on his
trunk. Several large, non-tender, mobile lymph nodes are palpated in the axillary
region. There is a slight reduction in breath sounds in all lung fields on respiratory
examination. Cardiovascular examination yields no significant findings except for mild
tachycardia. The spleen is noted to be firm and 7 cm below the left costal margin.
Chest x-ray reveals a mediastinal mass of 7 cm causing partial obstruction of the
trachea.
CBC
Hgb (g/L) Low
MCV N
Reticulocyte Count Low
WBC Low
Plt Low
View Slides
No Annotations: (To use Image Scope click the image of the slide with a magnifying glass)
To view slide with web browser click here
For Annotated slides:
To view slide click here
View Discussion and Diagnosis
Link
36Hemepath Case 35: 38-Year-Old Female
HISTORY
A 38-year-old female complains of a persistent dry cough of 3-month duration with
intermittent dyspnea. Four days ago she started noticing pain in her right lower leg.
She has felt increasingly feverish and tired over the past few weeks. Past medical
history is unremarkable.
On physical examination, the patient is noted to have a low-grade fever. The right leg is
slightly tender to palpation and multiple red, painful nodules are present on the anterior
aspects of both legs. Auscultation of the chest reveals coarse breath sounds bilaterally.
Imaging reveals bilateral hilar lymphadenopathy, diffuse reticular infiltrates, and
multiple nodules in both lung fields. Several nodular lesions are also observed on the x-
ray of the right tibia. Because of the CBC results, a bone marrow biopsy is performed.
CBC
Hgb (g/L) Low
MCV N
WBC Low
Plt Borderline low
View Slides
No Annotations: (To use Image Scope click the image of the slide with a magnifying glass)
To view slide with web browser click here
For Annotated slides:
To view slide click here
View Discussion and Diagnosis
Link
37Hemepath Case 36: 25-Year-Old Female
HISTORY
A 25-year-old female visits her family physician for an annual check-up. She is in good
health and reports no illnesses. Physical examination yields no significant findings. A
routine CBC is performed.
CBC
Hgb (g/L) N
MCV N
WBC N
Plt Severely low
View Slides
No Annotations: (To use Image Scope click the image of the slide with a magnifying glass)
To view slide with web browser click here
For Annotated slides:
To view slide click here
View Discussion and Diagnosis
Link
38Hemepath Case 37: 70-Year-Old Female
HISTORY
A 70-year-old female with a history of breast cancer presents with lethargy, and
lymphadenopathy of the axillary and supraclavicular regions.
CBC
Hgb (g/L) Low
MCV N
WBC Low
Plt N
View Slides
No Annotations: (To use Image Scope click the image of the slide with a magnifying glass)
To view slide 1 with web browser click here
To view slide 2 with web browser click here
For Annotated slides:
To view slide 1 click here
To view slide 2 click here
View Discussion and Diagnosis
Link
39Hemepath Case 38: 2-Year-Old Girl
HISTORY
A 2-year-old girl is brought in by her father. Two weeks ago, the child had a runny nose
and an unproductive cough, along with a low-grade fever. They visited the local clinic
and were diagnosed with a cold. The father bought some over-the-counter cold
medications but these did not seem to improve the girl’s symptoms.
Approximately a week ago, the girl began experiencing 15-20 intense bouts of coughing
per day, with each episode lasting a few minutes. The father remarks that the child’s
face turns bright red from coughing so hard.
CBC
Hgb (g/L) N
MCV N
WBC High
Plt High
View Slides
No Annotations: (To use Image Scope click the image of the slide with a magnifying glass)
To view slide with web browser click here
For Annotated slides:
To view slide click here
View Discussion and Diagnosis
Link
40Hemepath Case 39: 62-Year-Old Female
HISTORY
A 62-year-old female presents with chronic fatigue and an increased susceptibility to
infections. She has lost 10 pounds in the past month and experiences drenching night
sweats several times per week. Physical examination reveals large, rubbery lymph
nodes in the submandibular, cervical, and inguinal areas, as well as
hepatosplenomegaly.
CBC
Hgb (g/L) Low
MCV N
Reticulocyte Count Low
WBC Very high
Plt Low
View Slides
No Annotations: (To use Image Scope click the image of the slide with a magnifying glass)
To view slide with web browser click here
For Annotated slides:
To view slide click here
View Discussion and Diagnosis
Link
41Hemepath Case 40: 11-Year-Old Male
HISTORY
An 11-year-old male is brought in by his father. The boy has experienced intermittent
abdominal discomfort and nausea for the past week. Yesterday, the family was at the
swimming pool when the father noticed a mass protruding from the boy’s abdomen.
Physical examination reveals a pale, tired-looking boy in no apparent distress. Pinpoint
hemorrhages are noted on his arms. A firm abdominal mass of 15 cm is palpated in the
epigastric region. Fluid wave and shifting dullness are both present.
CBC
Hgb (g/L) Low
MCV N
Reticulocyte Count Low
WBC High
Plt Low
View Slides
No Annotations: (To use Image Scope click the image of the slide with a magnifying glass)
To view slide with web browser click here
For Annotated slides:
To view slide click here
View Discussion and Diagnosis
Link
42Hemepath Case 41: 33-Year-Old Male
HISTORY
A 33-year-old male who is HIV-positive presents with extreme fatigue and fever. His
partner notices that he is becoming increasingly pale. The patient also complains of
recurrent nosebleeds every 2-3 days, and remarks that his gums often bleed when he
brushes his teeth. He then shows you a petechial rash on his upper and lower
extremities.
CBC
Hgb (g/L) Low
MCV N
Reticulocyte Count Low
WBC Low
Plt Low
View Slides
No Annotations: (To use Image Scope click the image of the slide with a magnifying glass)
To view slide 1 with web browser click here
To view slide 2 with web browser click here
For Annotated slides:
To view slide 1 click here
To view slide 2 click here
View Discussion and Diagnosis
Link
43Hemepath Case 42: 13-Year-Old Boy
HISTORY
A 13-year-old boy presents with a history of “easy bruising”. You complete a full
history, and learn that there is blood in the patient’s urine from time to time;
additionally, the boy has been previously diagnosed with sensorineural deafness. The
patient’s mother and grandfather have similar problems.
CBC
Hgb (g/L) N
MCV N
WBC N
Plt Low
View Slides
No Annotations: (To use Image Scope click the image of the slide with a magnifying glass)
To view slide with web browser click here
For Annotated slides:
To view slide click here
View Discussion and Diagnosis
Link
44Hemepath Case 43: 25-Year-Old Female
HISTORY
A 25-year-old female receives a chest x-ray after being in an automobile accident.
Imaging reveals no organ damage or bone fractures from the collision; however,
enlargement of the mediastinum is noted. Subsequent CT of the chest shows a well-
circumscribed mediastinal mass with no evidence of infiltration.
The patient is in good health and reports no symptoms. She has an unremarkable past
medical history.
CBC
Hgb (g/L) N
MCV N
WBC N
Plt N
View Slides
No Annotations: (To use Image Scope click the image of the slide with a magnifying glass)
To view slide with web browser click here
For Annotated slides:
To view slide click here
View Discussion and Diagnosis
Link
45Hemepath Case 44: 17-Year-Old Male
HISTORY
A 17-year-old male visits his family physician. He has lost 10 lbs in the past 2 months,
and has experienced cyclic episodes of fever: 1-2 weeks of fever alternating with
afebrile periods. For the past few weeks, he has woken up in the middle of the night
with drenching night sweat, sometimes so severe that he has had to change his
pajamas. During the day, his entire body would feel incredibly itchy. The patient had
mononucleosis 1 year prior, but is otherwise in good health.
Physical examination reveals palpable cervical lymph nodes that are non-tender and
rubbery in consistency. Splenomegaly is also noted. There are multiple scratch marks
and excoriations throughout the patient’s body.
CBC
Hgb (g/L) Low
MCV N
WBC N
Plt Low
View Slides
No Annotations: (To use Image Scope click the image of the slide with a magnifying glass)
To view slide 1 with web browser click here
To view slide 2 with web browser click here
For Annotated slides:
To view slide 1 click here
To view slide 2 click here
View Discussion and Diagnosis
Link
46Hemepath Case 45: 26-Year-Old Male
HISTORY
A 26-year-old male exchange student from Central Africa presents with testicular pain
and cloudy urine. On physical examination, the patient is noted to be feverish. The
right scrotum and epididymis are enlarged and tender to palpation. The spermatic cord
is thickened. Painful inguinal lymphadenopathy and mild edema of the lower limbs are
also noted.
CBC
Hgb (g/L) Low
MCV N
WBC Mild increase. Differential shows mild eosinophilia
Plt N
View Slides
No Annotations: (To use Image Scope click the image of the slide with a magnifying glass)
To view slide with web browser click here
For Annotated slides:
To view slide click here
View Discussion and Diagnosis
Link
47Hemepath Case 46: 21-Year-Old Female
HISTORY
A 21-year-old female presents with red, 2-3 cm, non-pruritic targetoid lesions and bullae
on her trunk. Her buccal mucosa and lips are red and swollen, and especially painful
when she eats. Her conjunctivae are also inflamed. A few days prior, she had a sore
throat and experienced chills and fatigue, and thought she had the flu.
One week ago, she began taking Septra for a urinary tract infection. Past medical history
is noncontributory. There is no history of allergies, either environmental or drug-related.
CBC
Hgb (g/L) N
MCV N
WBC High
Plt N
View Slides
No Annotations: (To use Image Scope click the image of the slide with a magnifying glass)
To view slide with web browser click here
For Annotated slides:
To view slide click here
View Discussion and Diagnosis
Link
48Hemepath Case 47: Newborn Female
HISTORY
A female newborn presents with severe jaundice and hepatosplenomegaly. She is
tachycardic and tachypneic, and has marked peripheral edema.
CBC
Hgb (g/L) Low
MCV N
Reticulocyte Count High
WBC N
Plt N
OTHER LABORATORY FINDINGS
Serum Bilirubin (Unconjugated) High
View Slides
No Annotations: (To use Image Scope click the image of the slide with a magnifying glass)
To view slide with web browser click here
For Annotated slides:
To view slide click here
View Discussion and Diagnosis
Link
49Hemepath Case 48: Newborn Female
HISTORY
A female newborn, the product of an uneventful pregnancy, presents with physical
features consistent with trisomy 21, and is confirmed to have Down syndrome via
karyotype analysis. Upon further examination, the baby is noted to be slightly hypoxic,
with mild peripheral edema as well as hepatomegaly. A routine CBC is performed.
CBC
Hgb (g/L) Low
MCV N
WBC High
Plt High
View Slides
No Annotations: (To use Image Scope click the image of the slide with a magnifying glass)
To view slide with web browser click here
For Annotated slides:
To view slide click here
View Discussion and Diagnosis
Link
50Hemepath Case 49: 9-Year-Old Boy
HISTORY
A 9-year-old boy is brought in by his mother. The child has been complaining of double
vision and severe headaches since yesterday. He was diagnosed with acute
lymphoblastic leukemia 3 years ago, but has almost completed his maintenance therapy
without incident.
Right abducens nerve palsy and nuchal rigidity are demonstrated on physical
examination. A lumbar puncture, CBC, and bone marrow aspirate and biopsy are
quickly ordered. The peripheral blood smear and marrow findings are normal, showing
no evidence of leukemia or any other lesion. The CSF is shown in the digitized slide
below.
CBC
Hgb (g/L) N
MCV N
WBC N
Plt N
View Slides
No Annotations: (To use Image Scope click the image of the slide with a magnifying glass)
To view slide with web browser click here
For Annotated slides:
To view slide click here
View Discussion and Diagnosis
Link
51Hemepath Case 50: 22-Year-Old Woman
HISTORY
A 22-year-old woman has a routine CBC as part of an annual physician’s visit. She feels
well, and has no complaints. Her past medical history is notable only for an automobile
accident she had as a toddler: at that time she was hospitalized for several weeks, but
she has no memory of the accident itself.
CBC
Hgb (g/L) N
MCV N
Reticulocyte Count N
WBC N
Plt N
View Slides
No Annotations: (To use Image Scope click the image of the slide with a magnifying glass)
To view slide with web browser click here
For Annotated slides:
To view slide click here
View Discussion and Diagnosis
Link
52Hemepath Case 51: 3-Year-Old Boy
HISTORY
A 3-year-old boy is brought in by his mother. He has experienced recurrent seizures
and has a limp when he walks. The child has had frequent respiratory tract infections
and skin rashes ever since he was born. He burns quickly in the sun, and bleeds easily
with mild injuries. He is delayed developmentally. The child’s parents are first cousins.
On physical examination, the child is noted to have hypopigmented skin patches
throughout his body, and pale, almost silvery, hair. He is very sensitive to light from the
ophthalmoscope; fundoscopy reveals pale retinae. Neurological examination shows
reduced sensation in his left foot. The boy walks with an abnormal gait, and seems to
have trouble coordinating his movement.
CBC
Hgb (g/L) Low
MCV N
WBC Low
Plt N
View Slides
No Annotations: (To use Image Scope click the image of the slide with a magnifying glass)
To view slide with web browser click here
For Annotated slides:
To view slide click here
View Discussion and Diagnosis
Link
53Hemepath Case 52: 38-Year-Old Male
HISTORY
A 38-year-old male of Hispanic origin presents with a 3-day history of severe epistaxis.
There is no history of trauma and no family history of bleeding disorders. He is not
taking any medications or recreational drugs. The patient also complains of general
malaise, chills, and drenching night sweats. He had gingival bleeding 2 weeks ago,
which stopped after 10 days. On examination, the patient is noted to be feverish.
CBC
Hgb (g/L) Low
MCV N
Reticulocyte Count Low
WBC Low
Plt Low
View Slides
No Annotations: (To use Image Scope click the image of the slide with a magnifying glass)
To view slide with web browser click here
For Annotated slides:
To view slide click here
View Discussion and Diagnosis
Link
54Hemepath Case 53: 4-Year-Old Girl
HISTORY
A 4-year-old girl presents with oliguria, hematuria, and increasing irritability. The child
has a 1-week history of crampy abdominal pain, vomiting, and bloody diarrhea which
were just beginning to clear up when these new symptoms appeared. The child first
became sick after drinking unpasteurized apple juice.
On physical examination, the girl appears pale and restless. She is feverish and mildly
hypertensive. Her ankles are slightly swollen, and a petechial rash is noted on her legs
and arms.
CBC
Hgb (g/L) Low MCV N
Reticulocyte Count High
WBC High with left shift
Plt Low
OTHER LABORATORY FINDINGS
BUN High
Serum Creatinine High
Urinalysis Cellular casts with dysmorphic RBCs
View Slides
No Annotations: (To use Image Scope click the image of the slide with a magnifying glass)
To view slide with web browser click here
For Annotated slides
To view slide click here
View Discussion and Diagnosis
Link
55You can also read